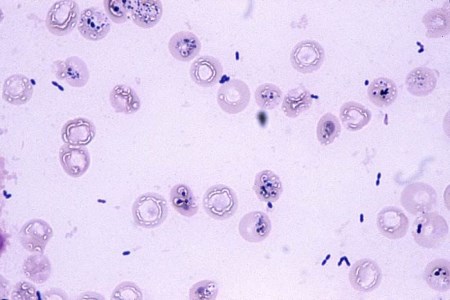

很多痛风患者身上会出现一些明显鼓起的包块——痛风石,痛风石大小不一,小的如芝麻,大的如鸡蛋。起初,它质地柔软,及时治疗可以逐渐缩小甚至消失。但久拖不治,随着纤维组织增生,它会越来越大。若痛风石破溃释会释放出石灰一般的结晶块,且破溃处极难愈合,一些病人甚至几年,十几年都无法愈合。

本期节目的患者因患上痛风,病情发展,导致全身多处关节长出痛风石,这些“大疙瘩”成为了患者这些年来的“心魔”,他因害怕别人说他是“怪物”,较后在家中躺了整整五年!这五年,他始终不敢出门,直到来院接受治疗……据成都风湿医院陈建春主任介绍,痛风石的成因,主要是痛风患者体内血尿酸水平一直居高不下,形成尿酸盐结晶,当结晶沉积在身体软组织等部位时,引起了慢性炎症和纤维组织增生,痛风石就生成了。他指出,如不积极进行溶石和有效降酸治疗,痛风石会沉积在人体很多部位,造成严重危害。

1、沉积在手足关节软骨处
痛风石不仅使关节外观狰狞、丑陋,而且会引起关节软骨退化性改变,导致血管翳的形成、滑囊增厚、软骨下骨质破坏,可发展为关节僵硬和关节畸形,直接影响到患者的关节功能。
严重的还会造成骨破坏、病理性骨折,患者较后只能进行人工关节置换术甚至截肢。
而破溃的痛风石由于血液供应差和长期磨损,外界与关节腔和骨髓直接相通,则会导致骨髓炎,严重时还会引发败血症或脓血症,较终死亡。
2、沉积在肾脏
在肾脏沉积则更加危险,如果还有肾动脉硬化、高血压、尿路结石和尿路感染等病症,病情就会进展迅速,很快发展到尿毒症阶段。

3、沉积在主动脉、主动脉瓣、二尖瓣、心肌等处
可引起心肌损害、冠状动脉供血不足、心律失常和心功能不全。

4、沉积在脊椎
可引起剧烈疼痛,伴有四肢麻木症状,还可出现畸形、椎管狭窄和脊髓压迫症。

5、沉积在眼部
可导致眼部慢性炎症、青光眼、失明等严重后果。

由于尿酸盐不易通过血脑屏障,所以除了中枢神经系统以外,几乎所有身体组织都容易形成痛风石。

通常患上痛风多久会出现痛风石?痛风石手术治疗的效果如何?怎样才能彻底清除痛风石?2017年11月8日CDTV-3《热线188》栏目将邀请我院医生陈建春主任为你现场讲解!节目详情敬请期待!
文章部分文字、图片、数据、视频等内容信息来源于互联网,版权归原作者所有,如有侵权请立即联系删除。